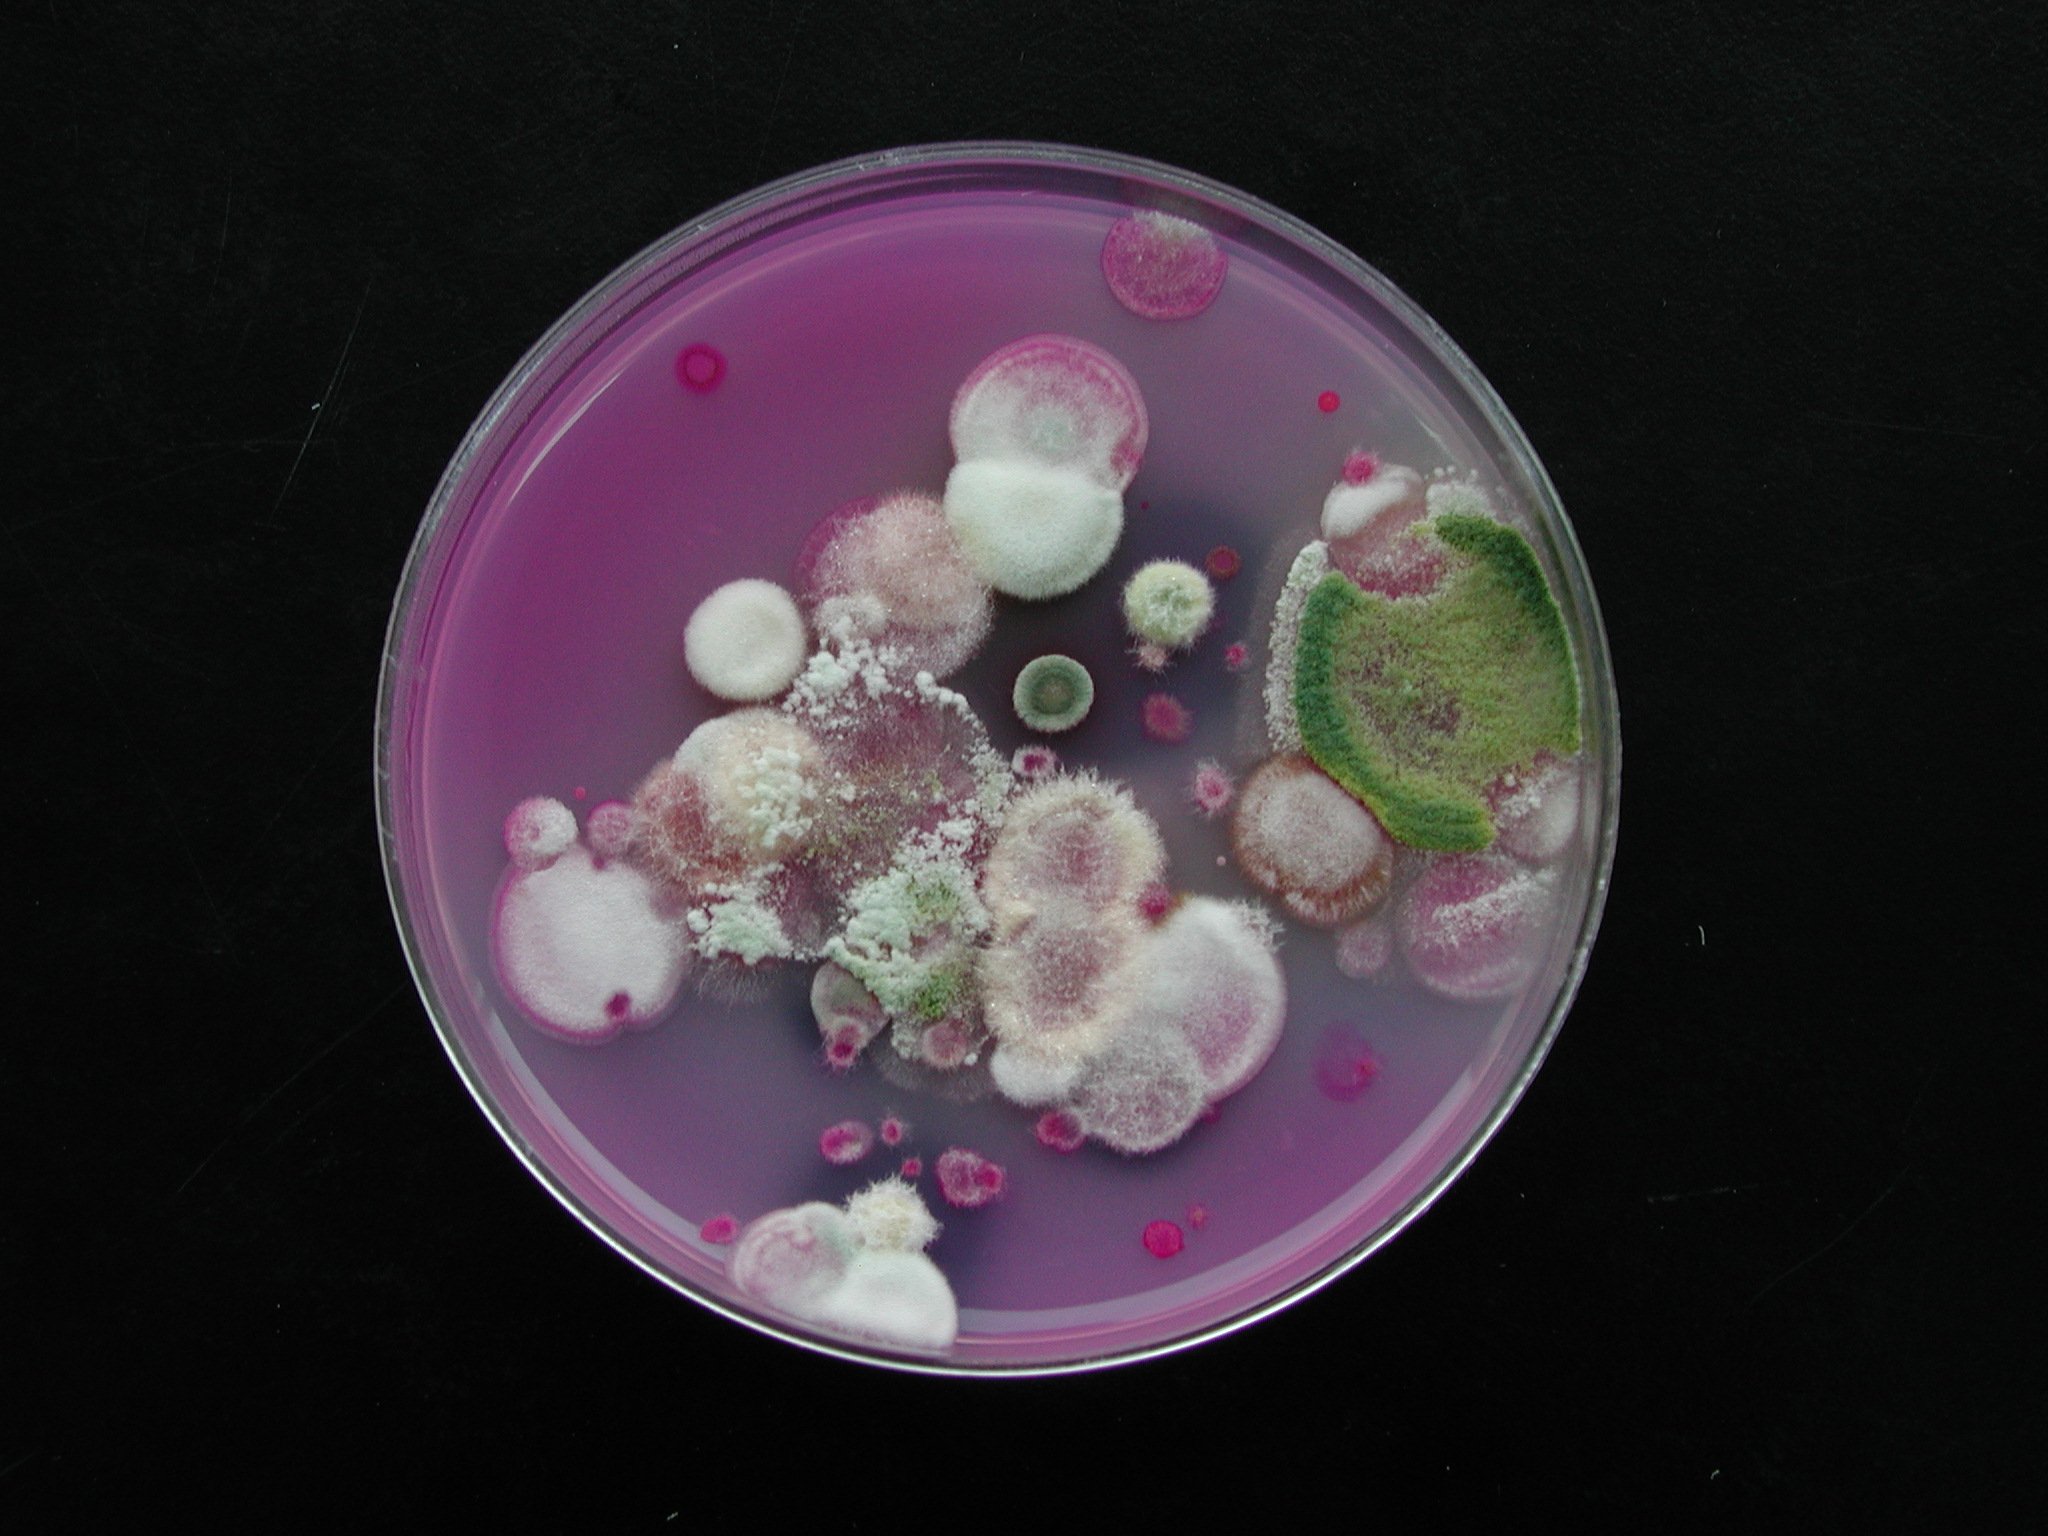

옷과 가죽 그리고 집에 곰팡이가 핀다는 것은
옷이나 직물 등의 대상물에
곰팡이가 이용할 수 있는 먹이와 수분이 있다는 것이다.
다시 말하여 기물이 깨끗하고 건조한 상태에서는
곰팡이가 피지 않음을 의미한다.
깨끗하다는 것은 곰팡이가 먹을 양분이 없다는 것이다.
말라 있다는 것은 사막처럼 식물이 살 수 없는 조건이라는 것이다.
옷이나 가죽 자체가 곰팡이의 먹이가 될 수 있지만,
옷이나 가죽 등의 기물에 묻어 있는 오염물질이
곰팡이 생육을 촉진하므로
건조한 상태가 유지되도록 하여야 한다.
이런 상태에서는 곰팡이의 생리적 특성상
곰팡이가 쉽게 자랄 수 없다.
레위기에 언급된 곰팡이는
주로 옷이나 가죽 또는 흙 속에 있는 유기물을 썩히는 작용을 하고,
종자를 부패시켜 파종할 수 없게 하는 것들이다.
그런데 집에 곰팡이가 생기면
집 안에 있는 옷 등 여러 기물을 오염시킬 뿐만 아니라,
집은 보통 밀폐된 공간이다 보니
곰팡이가 호흡기를 통해 인체 내로 들어가
면역력이 낮은 사람들에게 아스페르길루스증과 같은
곰팡이 병을 일으키는 경우가 발생한다.
따라서 주거 환경에 곰팡이가 생기지 않게 항상 주의하여야 한다.
옷과 가죽에 생기는 곰팡이(레위-13)
사람이 아플 때 증상이 외부로 드러나는 것에는 열이나 기침과 같이 신체의 자율적 반응에 따른 것과피부에 나타나는 여러 종류의 병징이 있다. 인체의 감염은 면역체계의 정상적인 흐름을 거
suhbundo.tistory.com
1. 옷과 가죽에 생기는 곰팡이(레위 13,47-59)
주님께서 모세와 아론에게 이르셨다(레위 13,1).
47“옷에 곰팡이가 생겨,
모직 옷이든,
아마포 옷이든,
48아마포나 모직으로 된 직물이든 편물이든,
또 가죽이든 가죽 물품이든,
49푸르스름하거나 불그스름한 병반이 그 옷이나 가죽에,
그 직물이나 편물에, 또는 어떤 가죽 제품에 나타나면,
그것은 곰팡이 병이므로 사제에게 보여야 한다.(레위 13,47-49)
옷, 직물 가죽 등에 곰팡이가 피었다는 것은
해당 기물에 묻어있는 양분과 수분 함량이
곰팡이의 생육 조건에 적합한 상태가 되었음을 뜻한다.
전문가의 진찰 및 처리 방법을 준수해야 한다.
주님께서 말씀하신다.
50사제는 그 병을 살펴보고 병든 물건을 이레 동안 따로 둔다.(레위 13)
병든 물건을 따로 보관한 다는 것은
환자를 격리한다는 것과 같다.
오염된 것을 격리시켜
다른 것들이 오염되지 않게 하는 1차적인 처리 단계이다.
병든 물건을 이레 동안 보관한다는 것은
병의 이행 유무를 확인하는 것이다.
7일 정도면 대부분의 호기성 곰팡이가
눈으로 확인될 수 있을 정도로 자랄 수 있는 기간이다.
실험실 조건에서,
곰팡이는 이틀 정도 지나면 맨눈으로 확인할 수 있다.
이 기간은 곰팡이가 계속 살아가는지
그렇지 않은지를 확인하는 기간이다.
주님께서 말씀하신다.
51이레째 되는 날에 병든 물건을 살펴보아,
옷이나 직물이나 편물에,
또는 어떤 용도로 쓰는 가죽 물품이든 그 가죽에 병이 번졌으면,
해로운 곰팡이 병이므로,
그 물건은 부정하다.
52그래서 병든 것은,
모직이나 아마포로 된 옷이든,
직물이든,
편물이든,
또는 어떤 가죽 제품이든 불에 태워야 한다.
그것은 해로운 곰팡이이므로 불에 태워야 한다.(레위 13,51-52)
곰팡이도 생물이기 때문에 양분이 없으면 살 수 없다.
그러므로 이레정도 지나도 계속 자란다면
대상 기물에 곰팡이가 살 수 있는 양분이 남아 있다는 것이다.
그래서 곰팡이는 계속 자라면서
씨앗이라 할 수 있는 포자를 형성한다.
곰팡이의 씨앗이라 할 수 있는 포자는
직물이나 가죽의 곳곳에 배어들게 된다.
이런 경우 살균제 살포와 같은 기술로
멸균할 수 없는 레위기 당시에
가장 좋은 방법은 소각 처리하는 것이다.
현재도 오염된 의료기구 및 각종 오염 물질이
소각 처리되기도 한다.
주님께서 말씀하신다.
53그러나 사제가 살펴보아,
그 옷이나 직물이나 편물에,
또는 어떤 가죽 제품에 그 병이 번지지 않았으면,
54사제는 병든 물건을 빨도록 지시하고,
다시 이레 동안 따로 두게 한다.(레위 13,53-54)
빨 수 있다는 것은 치료 가능성이 있다는 것이다.
옷에 묻어있는 이물질과
자라고 있는 곰팡이를
세탁이라는 물리적인 방법으로 제거하는 것이다.
그런데 이 방법으로는 완전 멸균을 할 수 없다.
그래서 세탁은 옷에 묻어있는 이물질의 양과
곰팡이 수를 줄이는 것에 불과하다.
우리가 세탁을 자주 하는 이유가 여기에 있다.
곰팡이의 먹이와 곰팡이 자체를
정기적으로 없애 주어야 하기 때문이다.
격리 상태에서 일주일을 기다리는 이유는
곰팡이의 재발 여부를 확인하는 것이다.
주님께서 말씀하신다.
55병든 물건을 빨아 놓은 뒤에 사제가 살펴보아,
그 병이 더 번지지 않았더라도 생김새가 바뀌지 않았으면,
그것은 부정하다.
안쪽이든 바깥쪽이든 파먹혀 들어간 그것을 불에 태워야 한다.
56그러나 그 물건을 빨아 놓은 뒤에 사제가 살펴보아,
그 병이 수그러졌으면,
그 옷이나 가죽,
또는 직물이나 편물에서 그 부분을 떼어 낸다.
57그 뒤에도 옷이나 직물이나 편물,
또는 어떤 가죽 물품에 병이 다시 나타나면,
그것은 퍼지고 있는 것이므로,
병든 물건을 불에 태워야 한다.(레위 13,55-57)
눈에 보이는 곰팡이는 주로 포자이다.
곰팡이가 핀 벽지,
혹은 과일, 빵 등을 나무젓가락 등으로 밀어보면
무언가가 묻어 나온다.
이렇게 묻어 나오는 것은 곰팡이 포자로
다음 번식을 위한 씨앗이다.
곰팡이는 옷이나 가죽 안으로
균사라는 것을 뻗어가며 자라기도 한다.
균사는 눈에 잘 보이지 않는다.
그렇기 때문에 균사가 살아 있으면
이병 조직에 있는 곰팡이가 변하지 않고 살아있는 상태를 유지한다.
그러므로 이러한 옷이나 가죽 같은 물건의 조직 안에는
곰팡이가 계속 살아있는 것이다.
그대로 놓아두면 또 다른 오염 및
다른 물건에 대한 2차 감염을 일으키는 감염원이 된다.
신속히 소각 처리해야 한다.


주님께서 말씀하신다.
58그러나 한 번 빤 뒤에 옷이나 직물이나 편물,
또는 어떤 가죽 제품에서 병이 사라졌을 때에는,
그것을 다시 빨면 정결하게 된다.
59이는 모직이나 아마포로 된 옷,
직물이나 편물,
또는 온갖 가죽 제품에 나타나는 곰팡이에 관한 법으로,
그 물건을 정결하다거나 부정하다고 선언하기 위한 것이다.”(레위 13,58-59)
세탁 후 이레가 지나도
병이 보이지 않으면 깨끗한 것이다.
곰팡이가 완전히 사라졌기 때문에
옷과 가죽을 계속 사용할 수 있다.
소유자에게 이렇게 말해야 한다.
"앞으로는 옷을 자주 빨아 입고,
가죽도 겉에 묻은 때를 잘 닦아내고 보관을 잘하시오!"
환자의 정결례 및 집에 생기는 곰팡이(레위-14)
집에 생긴 곰팡이에 대한 이야기가 나온다. 이는 광야에서의 천막이 아닌가나안 땅으로 들어가 살 때(레위 14,34)의 상황을 이야기한다. 그 당시 집에 생긴 곰팡이는현대의 벽지나 욕실 등에 핀
suhbundo.tistory.com
2. 집에 생기는 곰팡이(레위 14,33-57)
집에 생기는 곰팡이에 관한 내용은
레위기 시대의 주거 환경인 천막이 아니라,
앞으로 들어갈 가나안 땅에 있는 집에 대한 말씀이다.
본문 내용을 보면
레위기 시대의 가나안 지역의 집이
돌과 흙으로 지어졌음을 알 수 있게 한다.
주님께서 모세와 아론에게 이르셨다(레위 14,33).
34“내가 너희에게 소유로 주는 가나안 땅으로 너희가 들어갔을 때,
너희 소유가 된 그 땅의 어떤 집에
내가 곰팡이 병을 생기게 하면,
35그 집 임자는 사제에게 와서,
‘저의 집에 어떤 병 같은 것이 보입니다.’ 하고 알려야 한다.(레위 14,34-35)
비상 상황이 발생하면
당사자는 전문가에게 보고해야 한다.
전문가 및 방역 책임자에게 보고하지 않으면
자신의 집뿐만 아니라
인근 이웃들의 집까지 곰팡이가 번질 위험에 놓이게 된다.
따라서 자가 신고와 대응은 방역의 기본이다.
자가 신고를 적극적으로 하여야 한다.
당사자가 말하지 않으면
외부사람들이 쉽게 상황을 파악할 수 없기 때문이다.
주님께서 말씀하신다.
36사제는 자기가 그 병을 살펴보러 가기 전에
집을 비우도록 지시한다.
비우지 않으면
그 집 안에 있는 것이 모두 부정하게 된다.
그렇게 한 다음에
사제는 그 집을 살펴보러 간다.
37병든 곳을 살펴보아,
집 벽에 생긴 그 병이 푸르스름하거나 불그스름한 점으로 되어 있고,
다른 벽면보다 깊이 들어가 보이면,
38사제는 그 집 문밖으로 나와
이레 동안 그 집을 잠가 둔다.(레위 14,36-38)
방역 책임자는 즉시 출동하여
집안의 모든 물건을 밖으로 이동 조치하게 한다.
방역 초기에 이동이 가능한 것부터 격리하여
오염원으로부터의 감염 확산을 최소화시킨다.
그리고 조사에 들어가 확인 한 다음
이상 상황이 확인되면 대상 집을 폐쇄 조치한다.
전문가가 지속적으로 진행 상황을 관찰한다.
이때 집에 무단출입해서는 안된다.
무단 출입자는 병균의 전염원이 되어
외부로 확산시킬 수 있기 때문이다.
현대는 소독제가 있어 오염원을 제거할 수 있지만,
당시에는 이 방법 이외에는 적용할 수가 없었다.
오염원으로부터 스스로 자신을 격리하라!
주님께서 말씀하신다.
39이레째 되는 날에
사제가 다시 가서 살펴보아,
병이 그 집 벽에 번졌으면,
40사제는 병든 돌들을 빼내어 성읍 밖 부정한 곳에 버리도록 지시한다.
41또 그 집 안벽을 돌아가며 긁어내어,
긁어낸 흙도 성읍 밖 부정한 곳에 쏟아 버리게 한다.(레위 14,39-41)
흙으로 만든 집 안에 핀 곰팡이 병도
옷이나 직물처럼 양분이 없으면 소멸한다.
그런데도 계속 번졌다면
곰팡이 제거제가 없는 이상 방법은 긁어서 제거하는 것뿐이다.
곰팡이는
흙에 들어 있는 짚과 같은 유기물이 축축한 상태가 되면
자라면서 표면으로 포자를 만들고,
흙 속으로는 균사가 파고 들어가
흙과 마주하는 돌의 표면까지 오염시킬 수 있다.
그러므로 살균 방법이 없는 상황에서의 처치 방법은
병징이 나타난 부분의 흙을 긁어내고
돌을 빼내어 멀리 버리는 것뿐이다.
이는 병든 검체를 떼 내어 격리하는 것이다.
주님께서 말씀하신다.
42그러고 나서 다른 돌들을 가져다 그 돌들 대신 끼우고,
다른 흙을 가져다 그 집 벽에 바르게 한다.
43그 돌들을 빼내고 집 벽을 긁어내어 다시 바른 다음에,
그 병이 또 생겨 집에 퍼지면,
44사제가 가서 살펴본다.
그 병이 과연 집에 번졌으면,
그것은 집에 생긴 해로운 곰팡이다.
그 집은 부정하다.
45그러므로 그 집을 허물고
돌과 나무와 그 집의 흙을 모두
성읍 밖 부정한 곳에 내다 버리게 한다.(레위 14,42-45)
다른 돌로 갈아 끼우고
다른 흙으로 바른 후에도 병이 생겨 퍼진다면,
집 내부 전체가 감염되었거나,
새로 끼운 돌이나 흙 속에도 곰팡이가 있다는 것이다.
이는 집 주변의 상당한 범위가
곰팡이로 오염되어 있다는 것이다.
집을 격리할 수는 없고,
태울 수도 없는 흙과 돌로 된 집이라면
집을 허물어 집 지을 때 사용한 돌과 흙을 파내어
멀리 버릴 수밖에 없다.
지금은 집 지을 때 이러한 것들을 고려하여
항곰팡이성 건축 자재를 사용하거나,
환기가 잘되게 집을 짓지만,
그 당시에는 주변에 있는 흙과 돌들을 주로 사용하였기 때문에
주거지 주변 환경에서 유래한 곰팡이에 의해
재발할 가능성이 높다고 할 수 있다.
곰팡이는 세균과 달리 포자를 형성하기 때문에
오랜 기간 환경에 잔존할 수 있다.
그러므로 이러한 곰팡이들이
서식할 수 있는 조건이 되지 않게 하는 것이 중요하다.
그러나 레위기 당시에는
미생물이라는 개념을 잘 알지 못했기 때문에
예방적 차원에서
전문적으로 관리할 수 있는 상황은 아니었다.
주거 환경이 오염되면 곰팡이가 발생하므로
레위기에 나오는 내용처럼
오염된 물건들은 진영 밖 멀리 버리라는 규정을 준수하여
처리할 수밖에 없었을 것이다.
주님께서 말씀하신다.
46그 집을 잠가 둔 동안,
그 안에 들어가는 이는 저녁때까지 부정하게 된다.
47그 집에 누워 자는 이는 옷을 빨아야 하고,
그 집에서 음식을 먹는 이도 옷을 빨아야 한다.(레위 14,46-47)
집을 잠가 둔 동안에 들어갔다는 것은
현재의 기준으로 보면 방역법 위반이다.
집에 핀 곰팡이도 옷에 핀 곰팡이와 비슷한 종류이다.
따라서 오염된 집에 들어갔다면
집에 들억간 사람의 옷에 포자가 묻게 된다.
곰팡이 포자는 먼지처럼 공기 중에 떠다닐 수 있기 때문이다.
전문가 이야기를 듣지 않으면 자기만 손해지!
심지어 하느님께서도 말씀하시는데.
주님께서 말씀하신다.
48사제가 가서 살펴보아,
그 집을 다시 바른 다음에 그 집에 병이 번지지 않았으면,
병이 나은 것이므로 사제는 그 집을 정결한 것으로 선언한다.(레위 14,48)
방역 책임자의 지시에 따라
처치와 치유가 완료되면 원래의 일상으로 돌아간다.
현재의 보건학적 관점에서도
동일한 조치가 내려질 수밖에 없다.
가장 기본이 되는 관리 방법이기 때문이다.


'오경 > - 레위기 주제별 분류' 카테고리의 다른 글
| 반인륜적 죄악에 대한 말씀(레위 18장) (0) | 2022.02.24 |
|---|---|
| 보건 위생에 관한 말씀(레위 12; 13,1-46; 14,1-32; 15; 16장) (0) | 2022.02.22 |
| 식품 위생에 관한 말씀(레위 11장) (0) | 2022.02.20 |
| 거룩함이란(레위 8 - 10장) (0) | 2022.02.20 |
| 거룩한 삶으로 이끄는 예식(레위 1 - 7장) (0) | 2022.02.18 |